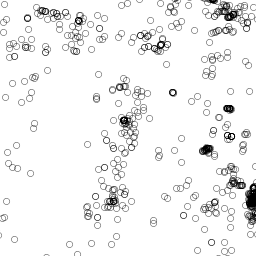

Arizona Geological Survey |
|
aasggeothermal_ORWellHeaders
http://services.azgs.az.gov/arcgis/services/aasggeothermal/ORWellHeaders/MapServer/WmsServer
| Service health Now: |
|---|
- Interface
- Web Service, OGC Web Map Service 1.3.0
- Keywords
- Well Headers, Well Log Depth, Geothermal, Oregon
- Fees
- none
- Access constraints
- unknown
- Supported languages
- No INSPIRE Extended Capabilities (including service language support) given. See INSPIRE Technical Guidance - View Services for more information.
- Data provider
-
Arizona Geological Survey (unverified)
Contact information:
Geoinformatics
Arizona Geological Survey
Postal:
416 W. Congress St., Suite 100, 85701 Tucson, USEmail:
Phone: 520-770-3500
- Service metadata
- No INSPIRE Extended Capabilities (including service metadata) given. See INSPIRE Technical Guidance - View Services for more information.
Ads by Google
WellHeaders in the state of Oregon
Available map layers (1)
Wellheader (Wellheader)
This layer contains data describing well headers in the state of Oregon, obtained by the AASG for the Geothermal Data Project. The data table includes general information on the location of the borehole, well construction information, location uncertainty and remarks. Information sources are included in the dataset. The HeaderURI for a particular borehole is the cross-referencing link (foreign key) used to associate the borehole with web based information on the well construction, pictures or other information, specific to one feature. The data is displayed using a circle with a transparent center. Layer files containing the symbology for these data layers can be found in the USGIN repository at http://repository.usgin.org/uri_gin/usgin/dlio/232.
There are currently no notifications for the service, click the feed icon to subscribe.